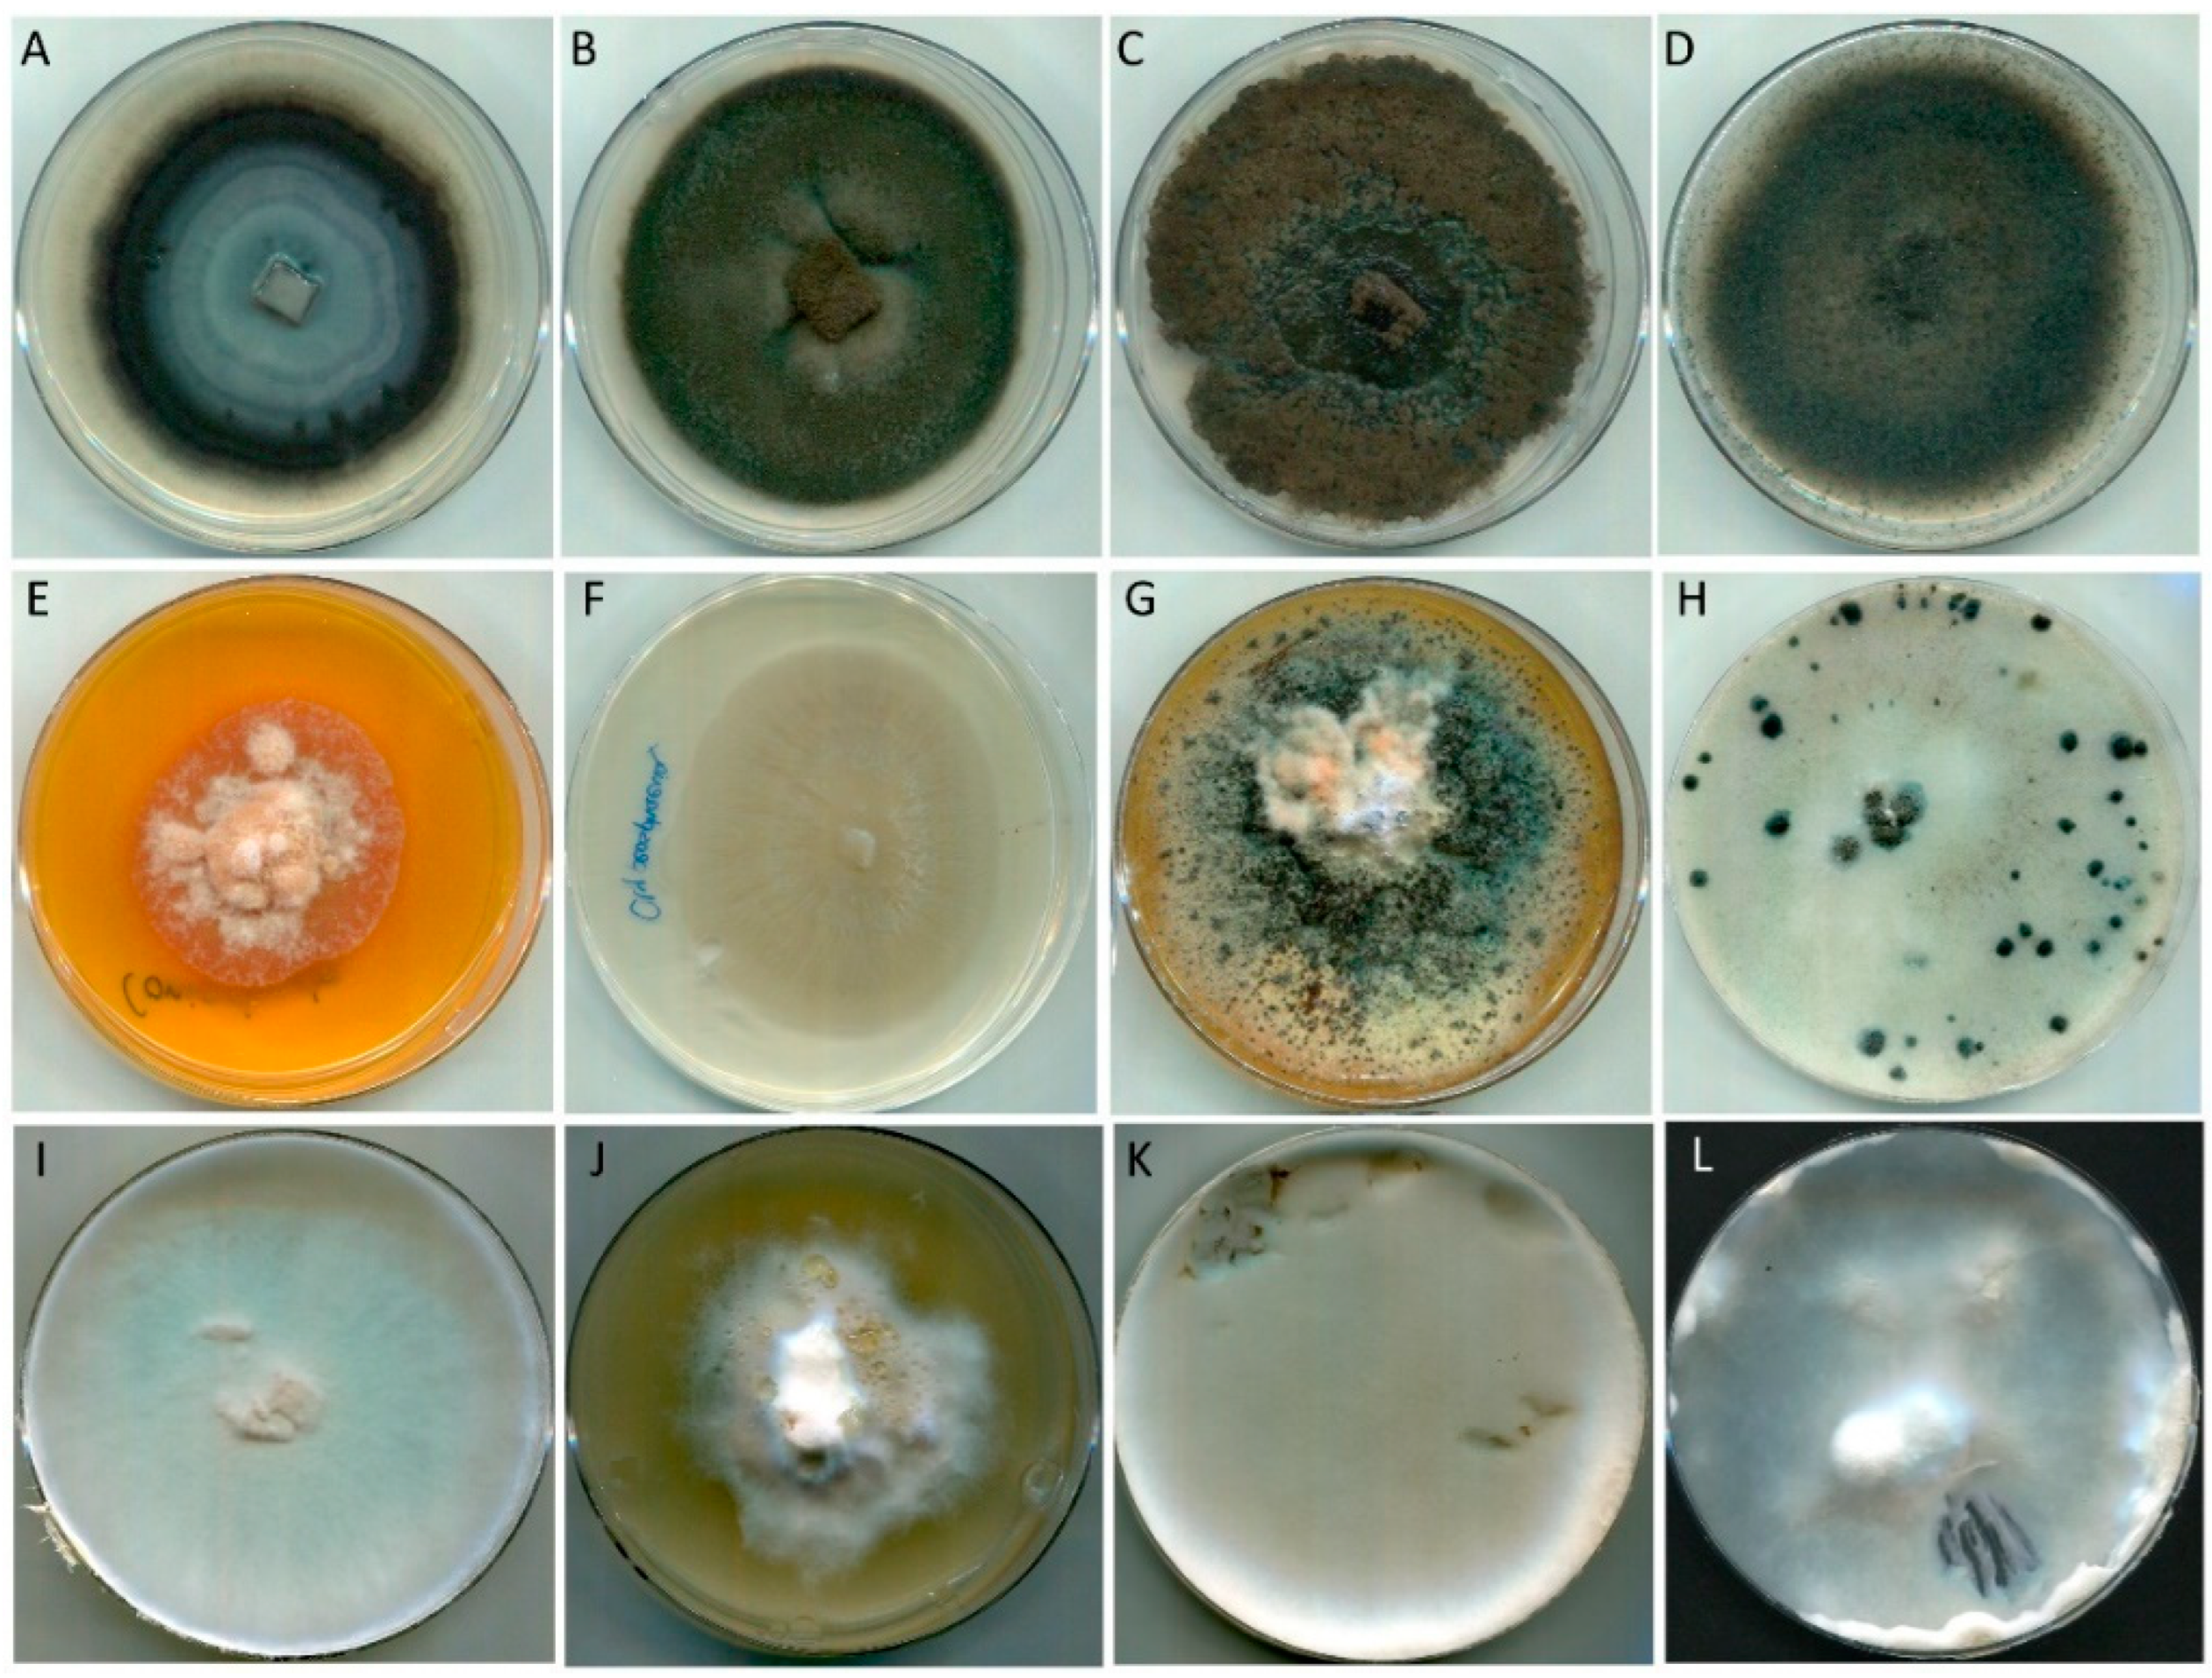
Forests 14 01338 g002 Forests 14 01338 g002

Fungal Colonization of Weathered Radiata Pine Surfaces Protected with Inorganic Nanoparticles and Coatings
Abstract
1. Introduction
2. Materials and Methods
2.1. Wood Samples
2.2. Impregnation with Nanoparticles
2.3. Coating Application
2.4. Weathering Exposure
2.5. Isolation and Identification of Fungi
2.6. Measurement of Colour Changes
2.7. Statistical Analyses of Data
3. Results
3.1. Effect of Treatment with Nanoparticles on Colour and Fungal Colonization of Uncoated Samples
3.2. Effect of Treatment with Nanoparticles on Colour and Fungal Colonization of Coated Samples
4. Discussion
5. Conclusions
Supplementary Materials
Author Contributions
Funding
Data Availability Statement
Acknowledgments
Conflicts of Interest
References
- Schacht, H. Ueber die Veranderungen durch Pilze in abgestorbenen Pflanzensellen. In Jahrbucher fur Wissenschaftliche Botanik; Verlag von August Hirschawald: Berlin, Germany, 1863. [Google Scholar]
- Möbius, M. Über graues und schwarzes Holz. Bot. Ges. 1924, 42, 341–344. [Google Scholar]
- Duncan, C. Role of microorganisms in the weathering of wood and degradation of exterior finishes. Off. Dig. Fed. Soc. Paint. Technol. 1963, 35, 1003–1012. [Google Scholar]
- Hansen, K. Molds and moldicide formulations for exterior paints and coatings. In Development of Commercial Wood Preservaties; ACS Symposium Series; American Chemical Society: Washington, DC, USA, 2008; Volume 982, pp. 198–213. [Google Scholar]
- Feist, W.C. Outdoor wood weathering and protection. In Archaeological Wood; American Chemical Society: Washington, DC, USA, 1990; pp. 263–298. [Google Scholar]
- Brisson, A.; Gharibian, S.; Eagen, R.; Leclerc, D.; Breuil, C. Localization and characterization of melanin granules produced by the sap-staining fungus Ophiostoma piceae. Mater. Org. 1996, 30, 23–32. [Google Scholar]
- Chedgy, R. The Role of Extractive Depletion in the Fungal Colonization of Western Redcedar. Master’s Thesis, University of British Columbia, Kelowna, BC, Canada, 2006. [Google Scholar]
- Evans, P.D. Weathering and Photoprotection of Wood. In Development of Commercial Wood Preservatives; ACS Symposium Series; American Chemical Society: Washington, DC, USA, 2008; Volume 982, pp. 69–117. [Google Scholar]
- Hernandez, V.A.; Evans, P.D. Technical note: Melanization of the wood-staining fungus Aureobasidium pullulans in response to UV radiation. Wood Fiber Sci. 2015, 47, 120–124. [Google Scholar]
- Savory, J. Effects of timber micro-organisms on paint performance. J. Oil Col. Chem. 1973, 56, 247–250. [Google Scholar]
- Evans, P.D.; Vollmer, S.; Kim, J.D.W.; Chan, G.; Kraushaar Gibson, S. Improving the Performance of clear coatings on wood through the aggregation of marginal gains. Coatings 2016, 6, 66. [Google Scholar] [CrossRef]
- Raberg, U.; Bijelovic, J.; Land, C.; Bardage, S.; Terziev, N. Identification of fungi colonising coated and modified wood exposed outdoors using sequencing and T-RFLP profiling. In Proceedings of the 37th Annual Meeting of IRG, Tromsoe, Norway, 18–22 June 2006; Document No: IRG/WP 06-20326. International Research Group on Wood Protection: Stockholm, Sweden, 2006. [Google Scholar]
- Pfeffer, A.; Hoegger, P.; Kües, U.; Militz, H. Fungal colonisation of outside weathered modified wood. Wood Sci. Technol. 2012, 46, 63–72. [Google Scholar] [CrossRef]
- Hashimoto, K.; Irie, H.; Fujishima, A. TiO2 photocatalysis: A historical overview and future prospects. Jpn. J. Appl. Phys. 2005, 44, 8269–8285. [Google Scholar] [CrossRef]
- Chen, F.; Yang, X.; Wu, Q. Antifungal capability of TiO2 coated film on moist wood. Build. Environ. 2009, 44, 1088–1093. [Google Scholar] [CrossRef]
- Chen, X.; Wu, Z.; Liu, D.; Gao, Z. Preparation of ZnO photocatalyst for the efficient and rapid photocatalytic degradation of azo dyes. Nanoscale Res. Lett. 2017, 12, 143. [Google Scholar] [CrossRef]
- Goffredo, B.; Citterio, B.; Biavasco, F.; Stazi, F.; Barcelli, S.; Munafò, P. Nanotechnology on wood: The effect of photocatalytic nanocoatings against Aspergillus niger. J. Cult. Herit. 2017, 27, 125–136. [Google Scholar] [CrossRef]
- Jain, A.; Vaya, D.; Jain, A.; Vaya, D. Photocatalytic activity of TiO2 nanomaterials. J. Chil. Chem. Soc. 2017, 62, 3683–3690. [Google Scholar] [CrossRef]
- Nevárez-Martínez, M.; Espinoza-Montero, P.; Quiroz-Chávez, F.; Ohtani, B. Fotocatálisis: Inicio, actualidad y perspectivas a través del TiO2. Av. Quimica 2017, 12, 45–59. [Google Scholar]
- Evans, P.D.; Matsunaga, H.; Preston, A.F.; Kewish, C.M. Wood protection for carbon sequestration—A review of existing approaches and future directions. Curr. For. Rep. 2022, 8, 181–198. [Google Scholar] [CrossRef]
- Fufa, S.M.; Jelle, B.P.; Hovde, P.J. Effects of TiO2 and clay nanoparticles loading on weathering performance of coated wood. Prog. Org. Coat. 2013, 76, 1425–1429. [Google Scholar] [CrossRef]
- Hernandez, V.A.; Romero, R.; Sagredo, N.; Contreras, D.; Evans, P.D. Studies of the photoprotection of radiata pine wood using photocatalytic nanoparticles. Forests 2022, 13, 1922. [Google Scholar] [CrossRef]
- Xu, A.; Gao, Y.; Liu, H. The preparation, characterization, and their photocatalytic activities of rare-earth-doped TiO2 nanoparticles. J. Catal. 2002, 207, 151–157. [Google Scholar] [CrossRef]
- Fernando, R. Nanomaterial technology applications in coatings. J. Coat. Technol. Res. 2004, 1, 32–38. [Google Scholar]
- Lim, Y.-W.; Kim, J.-J.; Chedgy, R.; Morris, P.; Breuil, C. Fungal diversity from western red cedar fences and their resistance to β-thujaplicin. Antonie Van Leeuwenhoek 2005, 87, 109–117. [Google Scholar] [CrossRef]
- Choi, Y.-W.; Hyde, K.; Ho, W.H. Single spore isolation of fungi. Fungal Divers. 1999, 3, 29–38. [Google Scholar]
- Barnett, H.L.; Hunter, B.B. Illustrated Genera of Imperfect Fungi; APS Press: St. Paul, MN, USA, 1998. [Google Scholar]
- Ganesh, S.; Cave, V. P-values, p-values everywhere! N. Z. Vet. J. 2018, 66, 55–56. [Google Scholar] [CrossRef] [PubMed]
- Seifert, K. Changes of the chemical wood components by blue rot Pullularia pullulans (de Bary) Berkout (= Aureobasidium pullulans (de Bary) Arnaud). Holz Roh- Werkstoff 1964, 22, 445–449. [Google Scholar]
- Dickinson, D. Disfigurement of decorative timbers by blue stain fungi. In Proceedings of the B.W.P.A. Annual Convention, Cambridge, UK; 1971; pp. 151–169. [Google Scholar]
- Schmidt, E.; French, D. Aureobasidium pullulans on wood shingles. Forest Prod. J. 1976, 26, 34–37. [Google Scholar]
- Amburgey, T. Organisms causing discoloration and deterioration of asphalt roofing shingles. Forest Prod. J. 1974, 24, 52–54. [Google Scholar]
- Bardage, S.L.; Bjurman, J. Isolation of an Aureobasidium pullulans polysaccharide that promotes adhesion of blastospores to water-borne paints. Can. J. Microbiol. 1998, 44, 954–958. [Google Scholar] [CrossRef]
- Held, B.W.; Jurgens, J.A.; Duncan, S.M.; Farrell, R.L.; Blanchette, R.A. Assessment of fungal diversity and deterioration in a wooden structure at New Harbor, Antarctica. Polar Biol. 2006, 26, 526–531. [Google Scholar] [CrossRef]
- Butler, M.; Day, A. Fungal melanins: A review. Can. J. Microbiol. 1998, 44, 1115–1136. [Google Scholar] [CrossRef]
- Butler, M.; Day, A. Pathogenic properties of fungal melanins. Mycologia 2001, 93, 1–8. [Google Scholar] [CrossRef]
- Fogarty, R.; Tobin, J. Fungal melanins and their interactions with metals. Enzyme Microb. Technol. 1996, 19, 311–317. [Google Scholar] [CrossRef]
- Henson, J.; Butler, M.; Day, A. The dark side of the mycelium: Melanin of phytopathogenic fungi. Annu. Rev. Phytopathol. 1999, 37, 447–471. [Google Scholar] [CrossRef]
- Hernandez, V.A. Role of Non-Decay Fungi on the Weathering of Wood. Ph.D. Thesis, University of British Columbia, Vancouver, BC, Canada, 2012. [Google Scholar]
- Rotem, J.; Aust, H. The effect of ultraviolet and solar radiation and temperature on survival of fungal propagules. J. Phytopathol. 1991, 133, 76–84. [Google Scholar] [CrossRef]
- Old, K.M.; Yuan, Z.Q.; Kobayashi, T. A valsa teleomorph for Cytospora eucalypticola. Mycol. Res. 1991, 95, 1253–1256. [Google Scholar] [CrossRef]
- Kang, J.C.; Hyde, K.D.; Kong, R.Y.C. Studies on the Amphisphaeriales I. The Clypeosphaeriaceae. Mycoscience 1999, 40, 151–164. [Google Scholar] [CrossRef]
- Holz, G.; Coertze, S.; Williamson, B. The Ecology of Botrytis on Plant Surfaces. In Botrytis: Biology, Pathology and Control; Elad, Y., Williamson, B., Tudzynski, P., Delen, N., Eds.; Springer: Dordrecht, The Netherlands, 2007; pp. 9–27. ISBN 978-1-4020-2626-3. [Google Scholar]
- Videira, S.I.R.; Groenewald, J.Z.; Braun, U.; Shin, H.D.; Crous, P.W. All that glitters is not Ramularia. Stud. Mycol. 2016, 83, 49–163. [Google Scholar] [CrossRef] [PubMed]
- Hlaiem, S.; Zouaoui, B.M.; Jamaa, B. Heterotruncatella spartii causal agent of dieback disease on Pinus pinea in Tunisia. Plant Pathol. Quar. 2019, 9, 192–197. [Google Scholar] [CrossRef]
- Kim, J.J.; Kang, S.M.; Choi, Y.-S.; Kim, G.-H. Microfungi potentially disfiguring CCA-treated wood. Int. Biodeterior. Biodegrad. 2007, 60, 197–201. [Google Scholar] [CrossRef]
- Terzi, E.; Kartal, S.N.; Yılgör, N.; Rautkari, L.; Yoshimura, T. Role of various nano-particles in prevention of fungal decay, mold growth and termite attack in wood, and their effect on weathering properties and water repellency. Int. Biodeterior. Biodegrad. 2016, 107, 77–87. [Google Scholar] [CrossRef]
- Lim, Y.-W.; Chedgy, R.; Amirthalingam, S.; Breuil, C. Screening fungi tolerant to western red cedar (Thuja plicata Donn) extractives. Part 2. Development of a feeder strip assay. Holzforschung 2007, 61, 195–200. [Google Scholar] [CrossRef]
- Zabel, R.; Morrell, J. Wood Microbiology: Decay and Its Prevention; Academic Press: San Diego, CA, USA, 1992. [Google Scholar]
- Mallet, K.; Hiratsuka, Y. Nature of the “black lines” produced between different biological species of the Armillaria mellea complex. Can. J. Bot. 1986, 64, 2588–2590. [Google Scholar] [CrossRef]
- Nakamura, Y.; Sungusia, M.G.; Sawada, T.; Kuwahara, M. Lignin-degrading enzyme production by Bjerkandera adusta immobilized on polyurethane foam. J. Biosci. Bioeng. 1999, 88, 41–47. [Google Scholar] [CrossRef]
- Schmidt, O. Indoor wood-decay basidiomycetes: Damage, causal fungi, physiology, identification and characterization, prevention and control. Mycol. Prog. 2007, 6, 261–279. [Google Scholar] [CrossRef]
- Franzén, I.; Vasaitis, R.; Penttilä, R.; Stenlid, J. Population genetics of the wood-decay fungus Phlebia centrifuga P. Karst. in fragmented and continuous habitats. Mol. Ecol. 2007, 16, 3326–3333. [Google Scholar] [CrossRef]
- Alshammari, N.; Stephenson, S.L. A preliminary study of wood-decay fungi in forests of northwest Arkansas. Curr. Res. Environ. Appl. Mycol. 2018, 8, 556–563. [Google Scholar] [CrossRef]
- Glazunova, O.A.; Shakhova, N.V.; Psurtseva, N.V.; Moiseenko, K.V.; Kleimenov, S.Y.; Fedorova, T.V. White-rot basidiomycetes Junghuhnia nitida and Steccherinum bourdotii: Oxidative potential and laccase properties in comparison with Trametes hirsuta and Coriolopsis caperata. PLoS ONE 2018, 13, e0197667. [Google Scholar] [CrossRef] [PubMed]
- Gauna, A.; Larran, A.S.; Feldman, S.R.; Permingeat, H.R.; Perotti, V.E. Secretome characterization of the lignocellulose-degrading fungi Pycnoporus sanguineus and Ganoderma resinaceum growing on Panicum prionitis biomass. Mycologia 2021, 113, 877–890. [Google Scholar] [CrossRef]
- Sahu, N.; Merényi, Z.; Bálint, B.; Kiss, B.; Sipos, G.; Owens, R.; Nagy, L. Hallmarks of basidiomycete soft- and white-rot in wood-decay -omics data of two Armillaria species. Microorganisms 2021, 9, 149. [Google Scholar] [CrossRef] [PubMed]
- Evans, P.D.; Urban, K.; Chowdhury, M. Surface checking of wood is increased by photodegradation caused by ultraviolet and visible light. Wood Sci. Technol. 2008, 42, 251–265. [Google Scholar] [CrossRef]
- Panshin, A.; De Zeeuw, C. Textbook of Wood Technology: Structure, Identification, Properties, and Uses of the Commercial Woods of the United States and Canada, 4th ed.; McGraw-Hill: New York, NY, USA, 1980. [Google Scholar]

| Label | Composition | Size | Bulk Density (g/cm3) |
|---|---|---|---|
| R50 | Rutile—TiO2 | 50 nm | 0.31 |
| R100 | Rutile—TiO2 | 100 nm | 0.37 |
| A40 | Antase—TiO2 | 40 nm | 0.42 |
| A100 | Antase—TiO2 | 100 nm | 0.65 |
| Z35 | ZnO | 35–45 nm | 0.48 |
| Z80 | ZnO | 80–200 nm | 0.48 |
| Label | Description | Composition Informed by the Manufacturer |
|---|---|---|
| B1 | Wood stabilizer | Light hydrotreated paraffinic distillates from petroleum, heavy aromatic solvent from naphtha, phosphoric acid ethylxilo esters, naphthalene, paraffinix wax, copper 8-quinolinol, 4,5-dichloro-2-octyl-3(2H)-isothiazolone |
| B2 | Varnish | UV protector, water repellent, fungicide |
| B3 | Wood protector | Sunflower, soy, and linseed oils, desiccant agents, propiconazole, solvent, aliphatic hydrocarbons |
| B4 | Marine varnish | Acrylic emulsion, organic solvents, special additives for UV protection, wide-spectrum biocide |
| B5 | Wood protector | Hydrocarbons C11-C14, C10-C13, isocyanates, aromatic compounds, zirconium salts, IPBC, acid 2 ethyl-hexanoic, and others |
| B6 | Marine varnish | Modified alkyd resins and special additives |
| B7 | Wood protector | Synthetic resins, mineral spirit, solar filters, water repellents, biocides |
| B8 | Marine varnish | Glycerol phthalic resin in aliphatic solvents, Stoddard, zircon oxide, and others |
| B9 | Protective coating for wood products | Alkyd resin with additives, aliphatic solvents, organometallic complex, inorganic pigments, solar filters protection factor 70, heavy naphtha, benzene, and others |
| Genera | Division | Uncoated Samples | Total Isolates * | ||||||
|---|---|---|---|---|---|---|---|---|---|
| No-NP | A40 | A100 | R50 | R100 | ZnO35 | ZnO80 | |||
| Aureobasidium sp. | Ascomycete | 3 | 3 | 2 | 2 | 3 | 3 | 3 | 19 (40.4) |
| Cladosporium sp. | Ascomycete | 1 | 1 | 1 | 1 | 4 (8.5) | |||
| Hormonema sp. | Ascomycete | 1 | 2 | 2 | 3 | 3 | 2 | 1 | 14 (29.8) |
| Alternaria sp. | Ascomycete | 1 | 1 (2.15) | ||||||
| Stereum sp. | Ascomycete | 2 | 2 (4.3) | ||||||
| Epicoccum nigrum | Ascomycete | 1 | 1 (2.15) | ||||||
| Sistotrema sp. | Ascomycete | 1 | 1 (2.15) | ||||||
| Cytospora eucalypticola | Ascomycete | 1 | 1 (2.15) | ||||||
| Armillaria sp. | Basidiomycete | 1 | 1 (2.15) | ||||||
| Burgella sp. | Basidiomycete | 1 | 1 (2.15) | ||||||
| Byssomerulius corium | Basidiomycete | 1 | 1 (2.15) | ||||||
| Terana caerulea | Basidiomycete | 1 | 1 (2.15) | ||||||
| Total number of isolates | 6 | 7 | 8 | 6 | 7 | 7 | 6 | 47 | |
| Diversity of genera isolated | 4 | 3 | 6 | 3 | 3 | 4 | 4 | 27 | |
| Genera | Division | Coated Samples | Total Isolates * | ||||||
|---|---|---|---|---|---|---|---|---|---|
| No-NP | A40 | A100 | R50 | R100 | ZnO35 | ZnO80 | |||
| Aureobasidium sp. | Ascomycete | 2 | 4 | 2 | 4 | 2 | 1 | 15 (23.4) | |
| Cladosporium sp. | Ascomycete | 2 | 2 | 1 | 3 | 1 | 2 | 3 | 14 (21.8) |
| Hormonema sp. | Ascomycete | 1 | 1 (1.56) | ||||||
| Alternaria sp. | Ascomycete | 1 | 1 | 1 | 1 | 4 (6.25) | |||
| Penicillium sp. | Ascomycete | 1 | 2 | 1 | 4 6.25) | ||||
| Botrytis cinerea | Ascomycete | 1 | 1 | 1 | 3 (4.7) | ||||
| Coniochaeta sp | Ascomycete | 1 | 2 | 3 (4.7) | |||||
| Bjerkandera sp. | Ascomycete | 1 | 1 | 1 | 3 (4.7) | ||||
| Stereum sp. | Ascomycete | 1 | 1 (1.56) | ||||||
| Epicoccum nigrum | Ascomycete | 1 | 1 (1.56) | ||||||
| Phlebia sp. | Ascomycete | 2 | 2 (3.12) | ||||||
| Sistotrema sp. | Ascomycete | 1 | 1 (1.56) | ||||||
| Trametes versicolor | Ascomycete | 1 | 1 | 2 (3.12) | |||||
| ClypeosphaeriaI sp. | Ascomycete | 1 | 1 (1.56) | ||||||
| Heterotruncatella sp. | Ascomycete | 1 | 1 (1.56) | ||||||
| Ramularia sp. | Ascomycete | 1 | 1 (1.56) | ||||||
| Valsa sp. | Ascomycete | 1 | 1 (1.56) | ||||||
| Ganoderma resinaceum | Basidiomycete | 1 | 1 (1.56) | ||||||
| Hyphodermella sp. | Basidiomycete | 1 | 1 (1.56) | ||||||
| Junghuhnia nitida | Basidiomycete | 1 | 1 (1.56) | ||||||
| Phanerochaetaceae sp. | Basidiomycete | 1 | 1 (1.56) | ||||||
| Skvortzovia pinicola | Basidiomycete | 1 | 1 (1.56) | ||||||
| Trechispora nivea | Basidiomycete | 1 | 1 (1.56) | ||||||
| Total isolates | 9 | 13 | 6 | 13 | 11 | 4 | 8 | 64 | |
| Diversity of genera isolated | 7 | 8 | 6 | 9 | 8 | 2 | 5 | 45 | |
Disclaimer/Publisher’s Note: The statements, opinions and data contained in all publications are solely those of the individual author(s) and contributor(s) and not of MDPI and/or the editor(s). MDPI and/or the editor(s) disclaim responsibility for any injury to people or property resulting from any ideas, methods, instructions or products referred to in the content. |
© 2023 by the authors. Licensee MDPI, Basel, Switzerland. This article is an open access article distributed under the terms and conditions of the Creative Commons Attribution (CC BY) license (https://creativecommons.org/licenses/by/4.0/).
Share and Cite
Hernandez, V.A.; Sagredo, N.; Riquelme, J.; Romero, R.; Evans, P.D. Fungal Colonization of Weathered Radiata Pine Surfaces Protected with Inorganic Nanoparticles and Coatings. Forests 2023, 14, 1338. https://doi.org/10.3390/f14071338
Hernandez VA, Sagredo N, Riquelme J, Romero R, Evans PD. Fungal Colonization of Weathered Radiata Pine Surfaces Protected with Inorganic Nanoparticles and Coatings. Forests. 2023; 14(7):1338. https://doi.org/10.3390/f14071338
Chicago/Turabian StyleHernandez, Vicente A., Nicole Sagredo, Javiera Riquelme, Romina Romero, and Philip D. Evans. 2023. "Fungal Colonization of Weathered Radiata Pine Surfaces Protected with Inorganic Nanoparticles and Coatings" Forests 14, no. 7: 1338. https://doi.org/10.3390/f14071338
APA StyleHernandez, V. A., Sagredo, N., Riquelme, J., Romero, R., & Evans, P. D. (2023). Fungal Colonization of Weathered Radiata Pine Surfaces Protected with Inorganic Nanoparticles and Coatings. Forests, 14(7), 1338. https://doi.org/10.3390/f14071338

